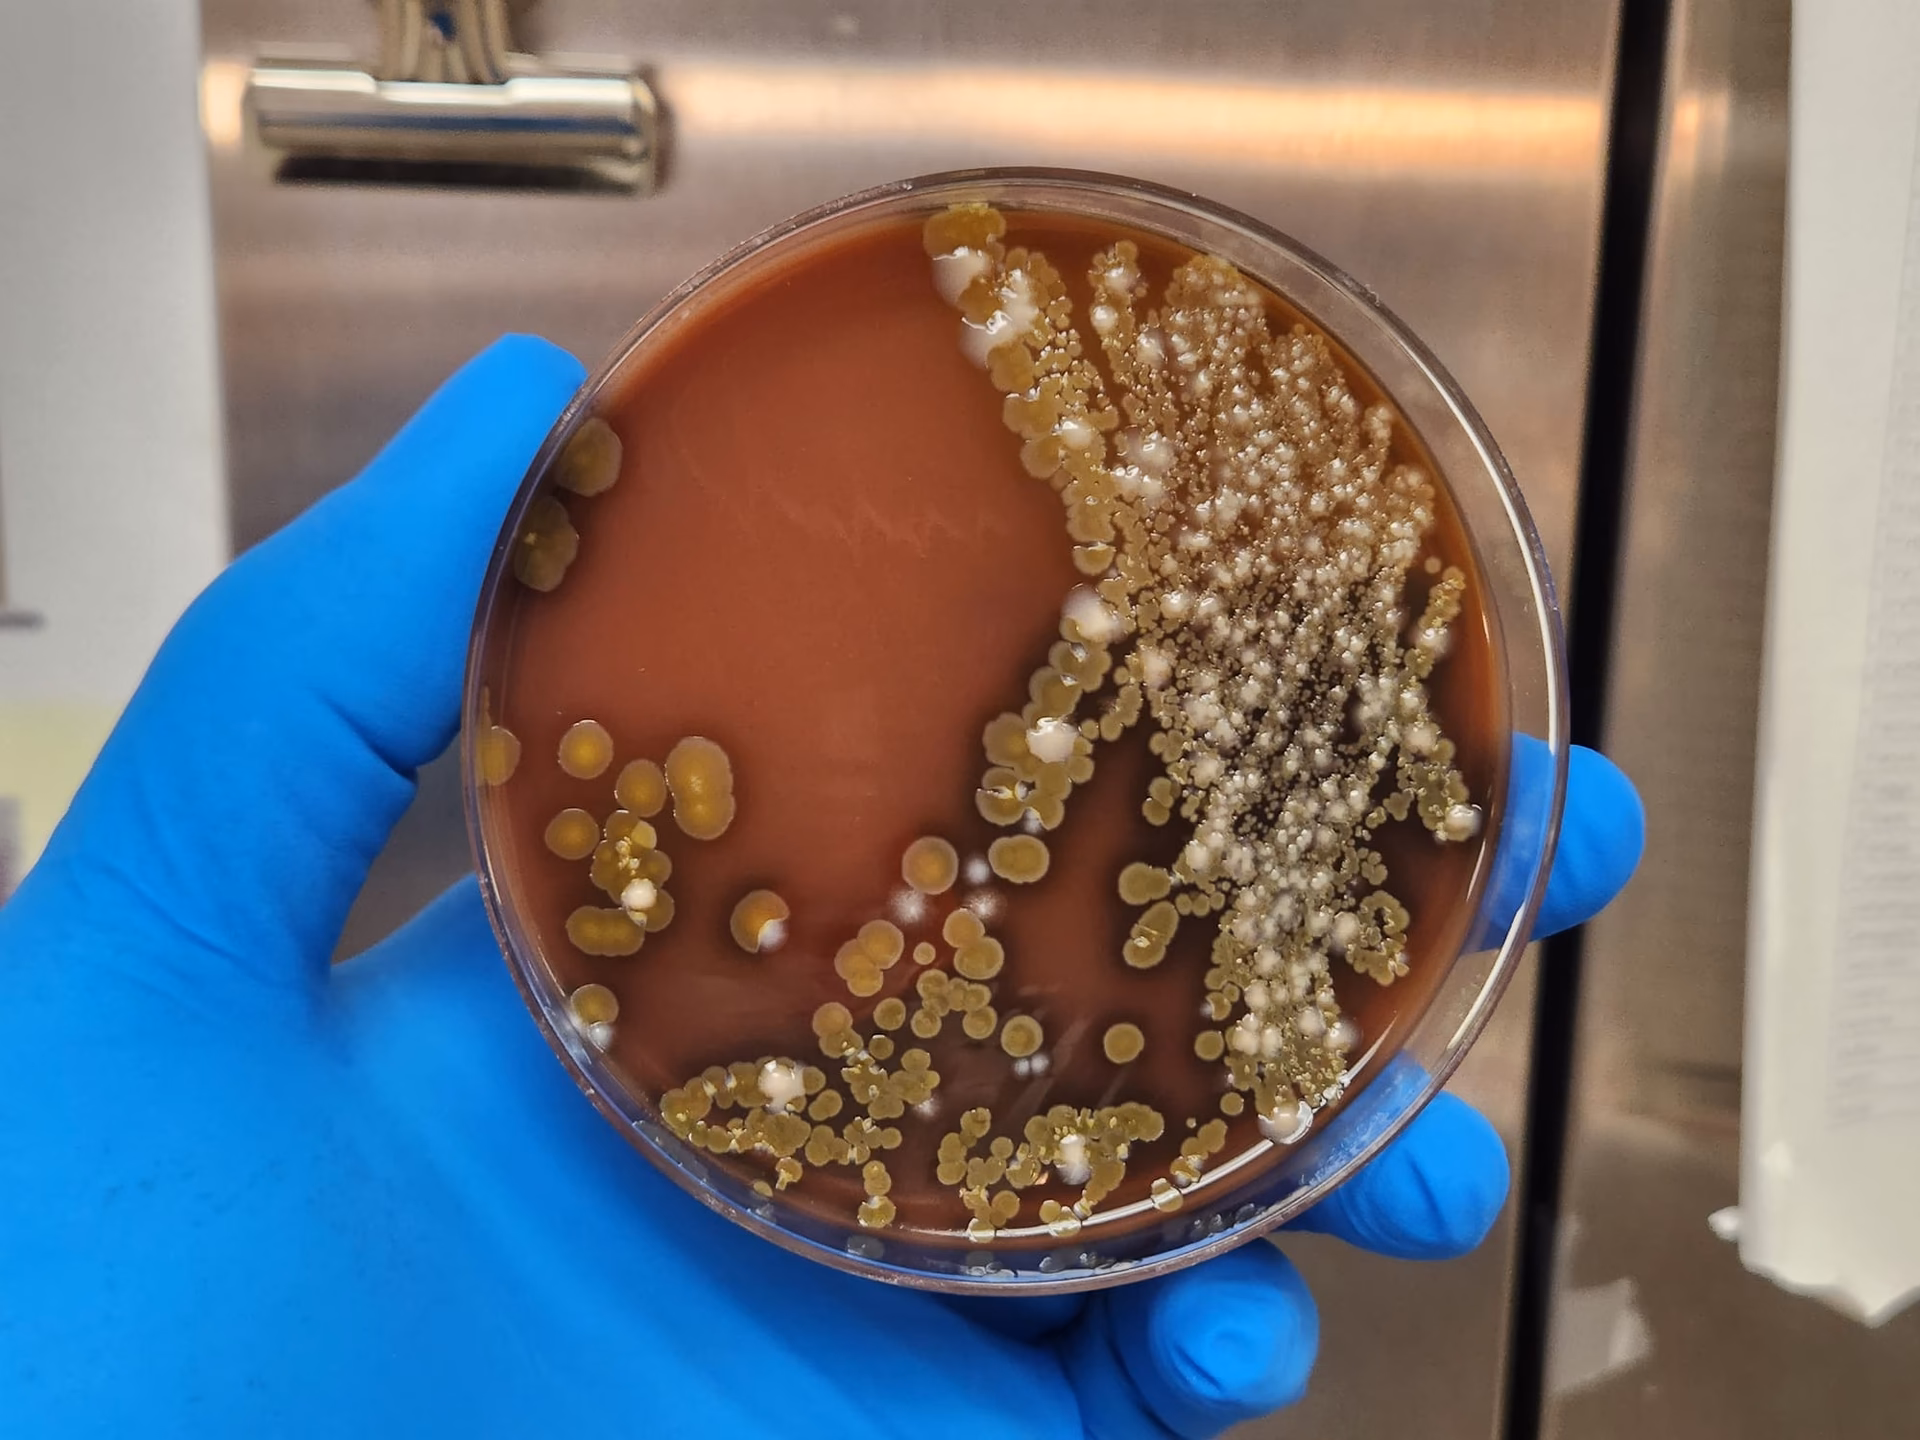
Does Acinetobacter baumannii cause nosocomial infections?

16/08/1999
En el vasto y microscópico mundo de las bacterias, pocas presentan una dualidad tan marcada como Acinetobacter lwoffii. Este microorganismo, un bacilo Gram-negativo, es un habitante común y silencioso de nuestro entorno e incluso de nuestro propio cuerpo. Para hasta un 25% de la población sana, esta bacteria forma parte de la flora normal de la piel, la orofaringe y el perineo, coexistiendo con nosotros sin causar ningún problema. Sin embargo, detrás de esta fachada de comensal inofensivo se esconde un patógeno oportunista, capaz de causar infecciones graves, especialmente en entornos hospitalarios y en pacientes con sistemas inmunitarios debilitados. Este artículo se sumerge en la compleja naturaleza de A. lwoffii, explorando desde su sorprendente capacidad de supervivencia hasta su emergente papel como causa de infecciones nosocomiales.

¿Qué es Exactamente Acinetobacter lwoffii?
Acinetobacter lwoffii es una bacteria que pertenece al género Acinetobacter. Históricamente, ha sido conocida por otros nombres, como Mima polymorpha o Acinetobacter calcoaceticus var. lwoffii, lo que a veces genera confusión en la literatura más antigua. Se clasifica como un bacilo Gram-negativo no fermentativo, lo que significa que no utiliza la fermentación para obtener energía, sino que depende del oxígeno para su metabolismo aeróbico.
Una de sus características más notables es su increíble resistencia ambiental. Es un microorganismo ubicuo, lo que significa que se puede encontrar en casi cualquier lugar. Su capacidad para sobrevivir en condiciones secas, a un pH bajo y en un amplio rango de temperaturas le permite colonizar una diversidad de nichos ecológicos. Se ha aislado en lugares tan dispares como el permafrost, antiguas minas de oro, alimentos congelados, tocino, huevos, leche pasteurizada y pescado. Esta robustez no solo le permite prosperar en la naturaleza, sino también en el ambiente hospitalario, donde la persistencia en superficies es un factor clave para la transmisión de infecciones.
De Habitante Común a Patógeno Nosocomial
La principal preocupación médica en torno a A. lwoffii no reside en su presencia en individuos sanos, sino en su capacidad para actuar como un patógeno nosocomial, es decir, una infección adquirida en un hospital. Los pacientes con sistemas inmunitarios comprometidos, aquellos ingresados en unidades de cuidados intensivos (UCI), los que reciben ventilación mecánica o los que portan catéteres intravenosos o urinarios son particularmente vulnerables.
Las infecciones asociadas a A. lwoffii incluyen:
- Bacteriemia: Infección del torrente sanguíneo, a menudo relacionada con catéteres. Es una de las manifestaciones más comunes y serias.
- Neumonía: Infección pulmonar, especialmente en pacientes con ventilación asistida.
- Meningitis: Inflamación de las membranas que rodean el cerebro y la médéu espinal.
- Infecciones del tracto urinario (ITU): Frecuentemente asociadas al uso de sondas urinarias.
- Infecciones de piel y heridas: Puede colonizar y complicar heridas quirúrgicas o quemaduras.
Aunque menos común, se ha documentado al menos un caso de gastroenteritis asociada a una bacteriemia por A. lwoffii adquirida en la comunidad, lo que sugiere que su potencial patogénico podría ser más amplio de lo que se pensaba inicialmente.
La Resistencia: Un Desafío Creciente
La notable capacidad de supervivencia de A. lwoffii se extiende a su resistencia frente a agentes antimicrobianos. Es intrínsecamente resistente a muchos desinfectantes, a la irradiación y a la desecación, lo que dificulta su erradicación de las superficies hospitalarias. Más preocupante aún es su creciente resistencia a los antibióticos.
Estudios han identificado cepas de A. lwoffiimultirresistentes (MDR), definidas como resistentes a más de cuatro clases de fármacos antimicrobianos. Por ejemplo, en un estudio retrospectivo de cuatro años en un hospital italiano, se encontraron cepas resistentes a todos los fármacos probados excepto a unos pocos de última línea como el imipenem, el meropenem y la amikacina. Generalmente, muestra resistencia a cefalosporinas (como cefepima, ceftazidima) y aztreonam. La aparición de estas cepas MDR complica enormemente el tratamiento y subraya la importancia de realizar pruebas de susceptibilidad para guiar la terapia antibiótica adecuada.
Tabla Comparativa: A. lwoffii como Comensal vs. Patógeno
| Característica | Perfil como Flora Normal (Comensal) | Perfil como Patógeno Oportunista |
|---|---|---|
| Población Afectada | Hasta el 25% de la población general sana. | Pacientes inmunocomprometidos, hospitalizados (especialmente en UCI), con catéteres o ventilación mecánica. |
| Hábitat Principal | Piel, orofaringe, perineo. Ambientes naturales (suelo, agua). | Superficies hospitalarias, dispositivos médicos (catéteres, ventiladores), heridas. |
| Impacto en la Salud | Generalmente nulo o inofensivo. Coexiste pacíficamente. | Causa de infecciones graves: bacteriemia, neumonía, meningitis, ITU. |
| Fuente de Infección | No aplicable, es parte de la flora. | Principalmente catéteres (intravasculares y urinarios). Transmisión nosocomial. |
| Mortalidad Asociada | Inexistente. | Baja si se retira la fuente (ej. catéter) y se administra tratamiento adecuado. |
Relación con Otras Especies de Acinetobacter
El género Acinetobacter es complejo, y a menudo es difícil diferenciar entre sus especies basándose únicamente en características fenotípicas. A. lwoffii es frecuentemente mencionado junto a A. baumannii y A. calcoaceticus. De hecho, a veces se agrupan en lo que se conoce como el complejo A. calcoaceticus-A. baumannii (ACB).

Si bien A. baumannii ha ganado notoriedad como uno de los patógenos nosocomiales más temidos y resistentes a nivel mundial, el papel de A. lwoffii no debe ser subestimado. Aunque históricamente se ha considerado menos virulento, la evidencia muestra claramente que es un agente causal significativo de bacteriemia en pacientes cateterizados e inmunocomprometidos. La vigilancia epidemiológica y la correcta identificación a nivel de especie son cruciales para entender la dinámica de las infecciones y aplicar las medidas de control más efectivas.
Preguntas Frecuentes (FAQ)
¿Es contagiosa la infección por Acinetobacter lwoffii?
No se considera contagiosa en el sentido tradicional, como un resfriado. La transmisión ocurre principalmente en entornos hospitalarios a través del contacto con superficies o equipos contaminados, o por la colonización de dispositivos médicos como los catéteres. No representa un riesgo para personas sanas en la comunidad.
Si tengo A. lwoffii en mi piel, ¿debería preocuparme?
No. Para la gran mayoría de las personas sanas, A. lwoffii es un componente normal e inofensivo de la microbiota de la piel. Solo se convierte en un problema cuando tiene la oportunidad de entrar en el cuerpo de una persona con defensas bajas, como a través de un catéter o una herida profunda.
¿Cómo se tratan las infecciones por A. lwoffii?
El tratamiento depende de la gravedad de la infección y de los resultados de las pruebas de susceptibilidad a los antibióticos. En muchos casos de bacteriemia asociada a catéteres, la simple retirada del dispositivo es un paso crucial y a veces suficiente. Cuando se requiere tratamiento antibiótico, se eligen fármacos a los que la cepa específica es sensible, que pueden incluir carbapenémicos (imipenem, meropenem) o aminoglucósidos (amikacina).
¿Puede encontrarse A. lwoffii en los alimentos?
Sí, su alta resistencia le permite sobrevivir en diversos productos alimenticios, incluyendo congelados y pasteurizados. Sin embargo, su presencia en alimentos no suele ser una causa común de enfermedad en personas sanas, aunque se ha reportado un caso aislado de gastroenteritis.
Conclusión
Acinetobacter lwoffii ejemplifica a la perfección la delgada línea que a veces separa a un microorganismo comensal de un patógeno peligroso. Su adaptabilidad y resistencia lo convierten en un superviviente nato, tanto en el permafrost ártico como en la aséptica superficie de una unidad de cuidados intensivos. Si bien para la mayoría de nosotros es un vecino silencioso, para los más vulnerables representa una amenaza real y creciente. Comprender su ecología, sus mecanismos de resistencia y sus vías de transmisión es fundamental para diseñar estrategias de prevención y control de infecciones que protejan a los pacientes y contengan la propagación de cepas multirresistentes en nuestros hospitales.
Si quieres conocer otros artículos parecidos a Acinetobacter lwoffii: Aliado y Amenaza Oculta puedes visitar la categoría Ecología.